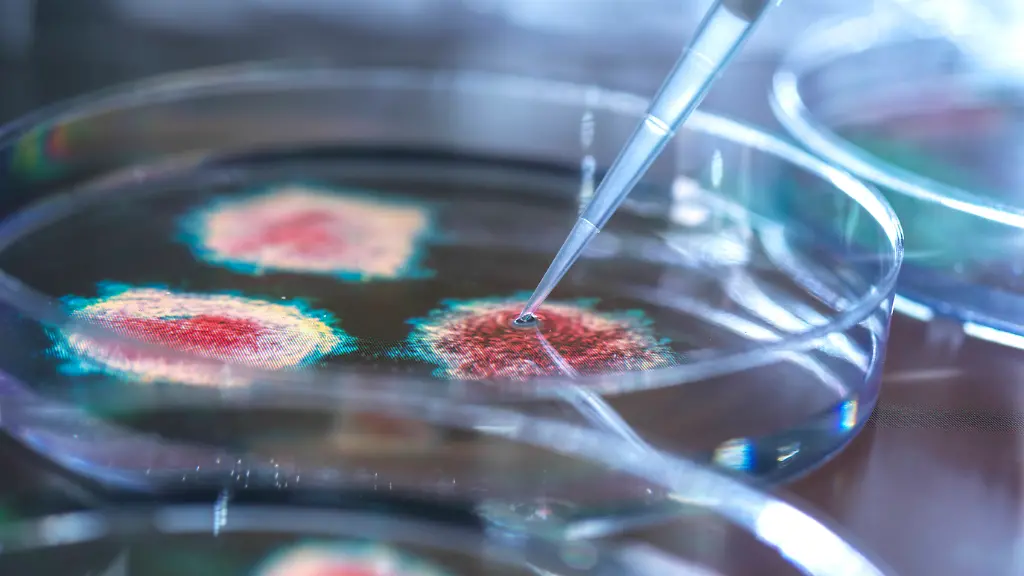
imago0102921804h-1

"Höchstwahrscheinlich Unfall"Forscher erklärt umstrittene Studie zu Labor-Ursprung von Sars-CoV-2
Mit einem Preprint zum mutmaßlich künstlichen Ursprung von Sars-CoV-2 sorgt ein Forschergespann für viel Wirbel. Aus der Fachwelt gibt es heftige Kritik. Im Gespräch mit ntv.de erklärt Mitautor Valentin Bruttel, warum das Erbgut des Virus aus seiner Sicht verdächtige Spuren aufweist.
Mit einem Preprint zum mutmaßlich künstlichen Ursprung des Coronavirus Sars-CoV-2 sorgt ein Forschergespann aus Deutschland und den USA für viel Wirbel. Sie kommen in ihrer Arbeit zu dem Schluss, dass das Virus sehr wahrscheinlich aus einem Labor stammt. Einer der Forscher ist Valentin Bruttel vom Universitätsklinikum Würzburg. Im Gespräch mit ntv.de erklärt er, wie er und seine Mitautoren, der Statistikexperte und Unternehmer Alex Washburn und Antonius VanDongen, Professor für Pharmakologie an der Duke-Universität in North Carolina, zu ihren verblüffenden Erkenntnissen kamen - und was er von der heftigen Kritik hält, die ihnen entgegenschlägt. Bruttel verrät auch, warum er das Risiko eingeht, sich mit einer Fragestellung zu beschäftigen, die oft als Verschwörungstheorie abgestempelt wird.
ntv.de: Herr Bruttel, Sie haben mit zwei Kollegen ein noch nicht unabhängig begutachtetes Preprint online gestellt, das eine ziemlich erstaunliche Aussage trifft. Demnach stammt Sars-CoV-2 sehr wahrscheinlich aus einem Labor. Wie sicher sind Sie sich dabei?
Valentin Bruttel: In Kombination mit anderen molekularen Hinweisen zeigen unsere Ergebnisse, dass dieses Virus zu 99,9 Prozent eine künstliche, wahrscheinlich manipulierte Kopie eines natürlichen Virus ist. Vereinzelte virologische Labore nutzen zur Herstellung solcher sehr umstrittenen synthetischen Viren sehr ähnliche Methoden, wie wir und viele andere sie zur Entwicklung proteinbasierter Medikamente in unserem Fall für Autoimmunerkrankungen nutzen.
Wie kommen Sie zu Ihrer Erkenntnis, dass Sars-CoV-2 wahrscheinlich künstlich manipuliert wurde?
RNA-Viren wie Coronaviren (RNA steht für Ribonukleinsäure. Sie trägt bei RNA-Viren die Erbinformation, Anm. d. Red.) sind sehr schwierig genetisch zu manipulieren. Wenn es gezielt sein soll, dann hat sich eine Methode etabliert, die darauf beruht, dass man zunächst das gesamt virale Genom auf DNA-Ebene (DNA steht für Desoxyribonukleinsäure. Sie trägt die Erbinformation bei allen Lebewesen und den DNA-Viren, Anm. d. Red.) zusammenstellt. Allerdings lassen sich auch auf DNA-Ebene die etwa 30.000 Nukleotide (die Grundbausteine der Nukleinsäuren, also der DNA und RNA, Anm. d. Red.) eines solchen Virusgenoms nicht einfach am Stück herstellen. Vor gut 20 Jahren wurde daher eine Methode entwickelt, die das gesamte Genom aus einzelnen Bausteinen zusammensetzt. Die etwa 30.000 Nukleotide werden dafür in fünf bis acht Bausteine aufgeteilt, die sich gut produzieren lassen oder heute einfach bestellt werden können.
Allerdings müssen diese Bausteine nachher im Reagenzgefäß wieder in der richtigen Reihenfolge zusammengebaut werden. Das gelingt dadurch, dass jeder Baustein ein klebriges Ende, einen kleinen Überhang einer der beiden DNA-Stränge, ein sogenanntes Sticky End, besitzt, das zu dem Sticky End des folgenden Bausteins passt. Um diese Sticky Ends zu produzieren, werden sogenannte Restriktionsenzyme verwendet, die DNA schneiden können. Damit die Bausteine sich richtig anordnen, muss sichergestellt werden, dass jede "Klebestelle" zwischen den Bausteinen nur einmal vorkommt. Deswegen wählt man hier von den tausenden Restriktionsenzymen nur solche, die verschiedene Sticky Ends produzieren können. Besonders geeignet sind jene des Typs IIS. Mit diesen lassen sich mit nur einem Enzym leicht die benötigten fünf bis acht Bausteine mit jeweils einzigartigen Sticky Ends produzieren. Die laut Herstellern gängigsten, von uns auch untersuchten wurden zum Beispiel benutzt, um in Wuhan in das Fledermaus-Coronavirus WIV1 verschiedene Spikeproteine (die Stachelproteine des Virus, Anm. d. Red.) einzusetzen.
Damit diese Enzyme jedoch erkennen, wo sie den DNA-Strang schneiden müssen, benötigen sie direkt neben den Sticky Ends sogenannte Erkennungsstellen, die meist sechs Nukleotide lang sind. Man kann diese Erkennungsstellen bei der Herstellung des Virus verschwinden lassen. Das wurde aber meist nicht gemacht, was es auch ermöglicht, einzelne Bausteine im fertig zusammengesetzten DNA-Genom später wieder auszutauschen. Und diese Erkennungsstellen in einem maximalen Abstand von etwa 8000 Nukleotiden findet man bei künstlich hergestellten Viren auch später im RNA-Genom.
Und diese Erkennungsstellen deuten auch bei Sars-CoV-2 auf eine Manipulation hin?
Es wurden ja bereits einige Viren künstlich verändert. Und man kennt da auch die natürlichen Vorbildviren aus der Natur, die nachgebaut wurden. Wir haben die Genome bekannter künstlich erstellter Viren mit jenen ihrer natürlichen Vorbildviren verglichen. In natürlichen Viren sind die Erkennungsstellen komplett zufällig verteilt, sie spielen keinerlei Rolle in der natürlichen Evolution der Viren, die ja nie mit diesen aus Bakterien stammenden Restriktionsenzymen in Berührung kommen. In den künstlichen Viren gibt es aber immer nur etwa vier bis sieben dieser Erkennungsstellen und sie haben vor allem keinen zu großen Abstand. Es entsteht quasi ein produktionsbedingtes Muster, ein Fingerabdruck. Auch bei Sars-CoV-2 findet man dieses Muster, in nah verwandten Viren jedoch nicht. Entscheidend ist, dass bei Sars-CoV-2 einige Veränderungen zu den Vorgängerviren nötig waren, um irgendein vergleichbar gut funktionierendes synthetisches Virussystem zu generieren. Unsere vorläufigen Ergebnisse haben ergeben, dass die Wahrscheinlichkeit, dass natürliche Evolution dieses Muster zufällig hervorgebracht hat, höchstens bei etwa 1 zu 100, wahrscheinlich weit darunter liegt.
Dann gibt es eine Reihe weiterer Hinweise. Diese Erkennungsstellen werden in künstlichen Viren immer durch sogenannte stille Mutationen eingebaut. Diese Mutationen verändern nur die Nukleotidsequenzen, nicht aber den von ihnen kodierten Proteinbaustein des Virus. Auch kleinste Veränderungen in den Proteinen könnten diese zum Beispiel völlig unbrauchbar machen und die nachfolgenden Experimente verfälschen. Und auch bei Sars-CoV-2 findet man im Vergleich zu natürlichen verwandten Viren nur stille Mutationen, die auch noch statistisch signifikant gehäuft in genau in diesen wenigen Erkennungsbereichen auftreten.
Und die von ihnen geschilderten Techniken waren vor Ende 2019, also vor dem Ausbruch der Pandemie, bereits verbreitet?
Ja, die ersten vergleichbaren RNA-Viren wurden, soweit ich weiß, schon im Jahr 2000 so hergestellt, im Labor von Ralph Baric (ein unter anderem für die Arbeit mit synthetisch veränderten Coronaviren bekannter US-Immunologe und Mikrobiologe, Anm. d. Red.).
Wie sind Sie auf die von Ihnen beschriebenen Besonderheiten im Erbgut von Sars-CoV-2 gestoßen?
Es wurden ja einige E-Mails veröffentlicht, aus denen erkennbar war, dass auch Virologen einen künstlichen Ursprung für wahrscheinlicher hielten. Ich habe erste Auffälligkeiten im Genom von Sars-CoV-2 im Sommer 2021 festgestellt und diese seitdem in meiner Freizeit weiter untersucht und diskutiert, vor allem mit meinem Mitautor Professor Antonius VanDongen. Dieser kennt sich besonders gut mit Analyseverfahren zum Vergleichen verschiedener Genome aus. Ich habe auch vermehrt versucht, Virologen auf diese Muster aufmerksam zu machen, was aber zu nichts führte. Dann ist Dr. Alex Washburn auf unsere Diskussion aufmerksam geworden und hat angeboten, die notwendigen Berechnungsmodelle und die statistische Auswertung auszuarbeiten, die nicht mein Fachgebiet sind. Wir haben diese dann zu dieser Vorab-Publikation ausgearbeitet.
Ist Ihre Arbeit ein Beweis für einen Labor-Ursprung des Virus? Oder eher ein starker Hinweis?
(zögert) Dieses Muster ist vergleichbar mit einem Fingerabdruck auf einer Tatwaffe. Wir haben gezeigt, dass es extrem unwahrscheinlich ist, dass ein solches Muster, das auch bei mindestens zehn anderen synthetischen RNA-Viren zu finden ist, hier rein zufällig auftaucht. Unsere Veröffentlichung konzentriert sich nur auf diesen Fingerabdruck.
Reicht das schon, um einen Laborunfall in Erwägung zu ziehen?
Persönlich denke ich, dass dieser Befund sich in eine Reihe weiterer sehr eindeutiger Hinweise auf einen Laborunfall einreiht, über die kaum berichtet wurde. Da ist etwa der Ursprungsort Wuhan, der weit weg entfernt ist von den Fledermauskolonien im Süden Chinas, wo die nahen Verwandten von Sars-CoV-2 vorkommen. Zu nennen ist auch die erstmals in einem solchen Virus aufgetauchte Furin-Schnittstelle, …
… eine Stelle am Spike-Protein des Virus, die nach Meinung von Forschern Sars-CoV-2 eine besonders hohe Infektiosität verleiht.
Richtig. Es ist aber nicht nur irgendeine, es ist eine, die genauso im Menschen vorkommt, im Protein ENaC-alpha. Es gäbe hunderte andere Möglichkeiten, zu einer funktionellen Furin-Schnittstelle zu kommen.
Und da wäre die Tatsache, dass die von uns beschriebenen Enzyme schon zuvor zur Manipulation von Fledermausviren im Labor von Shi Zhengli in Wuhan eingesetzt wurden. Und dann ist da eben der Forschungsantrag von 2018 unter Hauptantragsteller Peter Daszak, in dem Ralph Baric, Shi Zhengli und einige weitere gemeinsam planten, menschliche Furin-Schnittstellen in Sars-ähnliche Coronaviren einzubauen (der Antrag wurde allerdings abgelehnt, Anm. d. Red.). Dass ENaC-alpha von Furin gespalten wird, wurde an Barics Universität beschrieben. In dem Antrag wurde außerdem beschrieben, dass humanes ACE2 bindende Rezeptorbindedomänen in diese Fledermausviren aus Südchina eingebaut werden sollen. Im Vergleich zu einem anderen aus Wuhan publizierten verwandten Virus wie RaTG13 unterscheiden sich ausgerechnet die Furin-Schnittstelle und das Rezeptorbindemotiv außergewöhnlich stark, als wären sie eingefügt. Das von uns beobachtete Muster wäre ideal geeignet für solche Veränderungen.
Glauben Sie also, dass das Virus aus einem Labor in der Millionenstadt Wuhan entkam und vor Ort die Pandemie ausgelöst hat?
Das versuchen wir in unserem Preprint ausklammern und uns nur auf diesen "Fingerabdruck" zu konzentrieren. Wir treffen darin auch kein Aussage, welches Labor involviert sein könnte, die Informationen und Methoden waren ja öffentlich. So etwas sollte über eine Gesamtbetrachtung aller Fakten beurteilt werden, die jeder vielleicht anders gewichtet. Meine persönliche Einschätzung der Datenlage ist, dass zu 99,9 Prozent von einem künstlichen Ursprung, höchstwahrscheinlich einem unbeabsichtigten Unfall ausgegangen werden muss.
Nehmen wir mal an, es gab in Wuhan tatsächlich einen Laborunfall mit Sars-CoV-2. Wie hätte dieser denn ablaufen können?
Am Wuhan Institute of Virology wurde vor Beginn der Pandemie laut eigener Aussagen nur unter geringen Sicherheitsbedingungen an Coronaviren gearbeitet, auch auf biologischer Sicherheitsstufe 2, bei der nicht mal ein Mund-Nase-Schutz zwingend vorgeschrieben ist. Da kann so etwas meiner Einschätzung nach relativ leicht passieren, aber da sollten Sie Experten fragen. Ein Forscher könnte von einer Maus gebissen worden sein, etwas fällt herunter oder es bilden sich Aerosole. Ein junger Mitarbeiter hat sich vielleicht unwissentlich infiziert, keine Symptome gehabt und weitere Menschen angesteckt. Das Virus könnte theoretisch von asymptomatisch Infizierten nahezu überall in die Stadt gelangt sein, um dann, den Gensequenzanalysen anderer nach, Monate später auf dem Huanan-Nassmarkt in Wuhan erstmals bei einem großen Superspreader-Event in Erscheinung zu treten.
Ihre Vorab-Publikation hat ja bereits kurz nach der Öffentlichmachung heftigen Gegenwind von Virologen auf Twitter geerntet. Unter anderem wurde kritisiert, dass man bei einer künstlichen Manipulation des Erbgutes eines Virus die Erkennungsstellen auch verstecken könnte.
Das ist richtig. Es gibt dafür die sogenannte No-See'm-Technik. Aber diese hat den Nachteil, dass man in ein einmal zusammengesetztes DNA-Genom keine weiteren Veränderungen über diese Schnittstellen einbauen kann. Außerdem wurde diese Technik nur selten vor 2019 für ähnliche Viren eingesetzt, meist findet man die Schnittstellen im künstlichen Genom. Unsere Arbeit ist aber auch nicht als hundertprozentig abgeschlossen zu betrachten, eine Vorveröffentlichung dient auch dazu, Verbesserungsvorschläge oder Korrekturen noch mit einzuarbeiten. Wir werten nun also konstruktive Rückmeldungen oder Kritiken von anderen Experten aus, ergänzen das Manuskript, und dann wird alles nochmal im Peer-Review-Prozess von Kollegen für eine Zeitschrift im Detail durchleuchtet. Wir wollen natürlich auch wissen, ob uns technische Fehler oder Denkfehler unterlaufen sind. Ich bin für jede vernünftige Kritik offen.
Der bekannte Forscher Kristian Andersen hat Ihre Studie auf Twitter sogar als "Nonsens" bezeichnet. Sie sei "so fehlerhaft, dass sie nicht einmal in einem molekularbiologischen Kindergarten bestehen würde". Im Erbgut von Sars-CoV-2 sei lediglich "zufälliges Rauschen" zu erkennen. Was sagen Sie dazu?
Leider wird oft auf Beleidigungen zurückgegriffen, was ich befremdlich finde. Herr Andersen und andere Virologen haben mich auf Twitter sogar blockiert, so dass ich deren Kommentare erstmal gar nicht sehe und nicht darauf reagieren kann. Ich habe die Argumente inzwischen zum Teil gesehen, auf den ersten Blick ist da nichts Substanzielles dabei. Ein anderer Virologe hat zum Beispiel basierend auf Sars-CoV-2 ein Vorgängervirus am Computer modelliert, in welches viele Teile und damit auch eine entfernte Schnittstelle übernommen wurden. Diese erste entfernte BsaI-Schnittstelle ist in allen wirklich existierenden verwandten Viren noch da. Sein Argument ist jetzt, dass zum Beispiel das Fehlen dieser Schnittstelle in Sars-CoV-2 nicht außergewöhnlich ist, weil sie ja in dem an dieser Stelle aus Sars-CoV-2 kopierten Virus auch fehlt. Professor Andersen hat übrigens in internen E-Mails selbst geschrieben, dass einige Eigenschaften von Sars-CoV-2 auf einen künstlichen Ursprung hinweisen, und dann nie erklärt, welche Daten ihn bewogen haben, Tage später zu publizieren, Sars-CoV-2 sei ganz sicher natürlichen Ursprungs. Professor Friedemann Weber (Leiter des Instituts für Virologie an der Universität Gießen, Anm. d. Red.) sagt, dass man ein solches Virus zusammensetzen würde, ohne dass man die Schnittstellen später sieht. Unsere Argumente, warum man genau das nicht machen würde, wenn man, wie in Wuhan geplant, sehr viele Rezeptorbindedomänen oder Furin-Schnittstellen testen will, wurden wohl übersehen.
Es gab aber auch viel positives Feedback und konstruktive Kritik, zum Beispiel hält Professor Richard Ebright (Molekularbiologie an der Rutgers University im US-Bundesstaat New Jersey, Anm. d. Red.) unsere Vorabpublikation für bemerkenswert und hat gute Kritikpunkte vorgebracht. Professor Francois Balloux (Direktor des Genetics Institute am University College London, Anm. d. Red.) konnte keine Fehler erkennen und stimmt den Kernaussagen zu. Es gab schon viele kleinere, sehr hilfreiche Anmerkungen und einige Punkte müssen von uns wohl auch einfach viel detaillierter erklärt und ausführlicher diskutiert werden, wir wollten das Paper nicht überladen. Das benötigt jetzt einfach etwas Zeit, aber es steht ja auch jedem offen, diese Beobachtung selbst zu diskutieren.
Gäbe es denn eine Entdeckung zu Sars-CoV-2, die Ihre Meinung, dass es vermutlich künstlich erschaffen wurde, ändern würde?
Klar. Wenn etwa eine wirklich unabhängige Kommission ohne Interessenskonflikte nach China reist, systematisch die Tierwelt durchsucht und dabei ein Vorgängervirus findet, aus dem Sars-CoV-2 plausibel entstanden sein könnte, ändert sich natürlich die Datenlagen. Wobei selbst so etwas auch fingiert werden könnte. Die bisherige offizielle Untersuchungskommission zum Ursprung von Sars-CoV-2 der WHO durfte ja nicht mal wirklich in die Labore und wurde von genau dem Peter Daszak geleitet, der als Hauptantragsteller plante, in Wuhan Furin-Schnittstellen in Fledermausviren einsetzen zu lassen.
Außerdem wurde ja schon genau ein solcher möglicher Vorfahr aller Sars-CoV-2-Linien gefunden. Nur befand sich in der Probe keine DNA von Zwischenwirten, sondern von Laborzelllinien, die immer bei der Herstellung und manchmal bei der Testung synthetischer Viren eingesetzt werden. Das wurde dann meiner Erkenntnis nach nicht wirklich in der Öffentlichkeit diskutiert und ist so vielleicht vielen Virologen auch nicht bekannt.
Die Überlegung, dass Sars-CoV-2 aus einem Labor stammt, wird immer wieder auch als Verschwörungstheorie bezeichnet. Gehen Sie nicht ein gewisses Risiko als Forscher ein, wenn Sie mit so einem Preprint an die Öffentlichkeit gehen?
Natürlich ist es ein gewisses persönliches Risiko. Professor Roland Wiesendanger wurde ja zum Beispiel für seine Quellenstudie und Materialsammlung in der Öffentlichkeit ziemlich hart angegangen. Aber wie hoch wäre denn das Risiko für uns alle, eine solche Beobachtung einfach nicht öffentlich zu diskutieren? Erst kürzlich wurde in Boston auch unter Mitwirkung deutscher Virologen ein chimäres Virus geschaffen, das wohl die höhere Tödlichkeit des ursprünglichen Sars-CoV-2 mit der besseren Ansteckungsfähigkeit und der Resistenz gegen Impfstoffe von Omikron kombiniert. Dabei wurde wohl ignoriert, dass für solche Experimente Genehmigungen notwendig sind, die Förderorganisation wurde wohl überhaupt nicht über das Vorhaben informiert. Und Sars-CoV-2 ist ja auch um ein Vielfaches weniger tödlich als die meisten Viren, die künstlich im Labor hergestellt oder manipuliert wurden. In Rotterdam wurde zum Beispiel ein fast hundertfach tödlicheres Virus im Labor so verändert, dass es wahrscheinlich sehr gut von Mensch zu Mensch übertragbar wird.
Ich würde das ganze Thema am liebsten sofort liegen lassen und in meiner Freizeit endlich wieder mehr andere Dinge tun. Aber der technische Fortschritt ermöglicht es heute Forschern, mit wenigen tausend Euro nach öffentlichen Protokollen in wenigen Wochen ein Virus herzustellen, das nicht nur unsere medizinischen Versorgungssysteme komplett zusammenbrechen lassen könnte. Genau wie unsere Vorveröffentlichung jetzt in Ruhe diskutiert werden muss, sollte diese neue Gefahr dringend auch in der breiten Öffentlichkeit diskutiert werden.
Mit Valentin Bruttel sprach Kai Stoppel